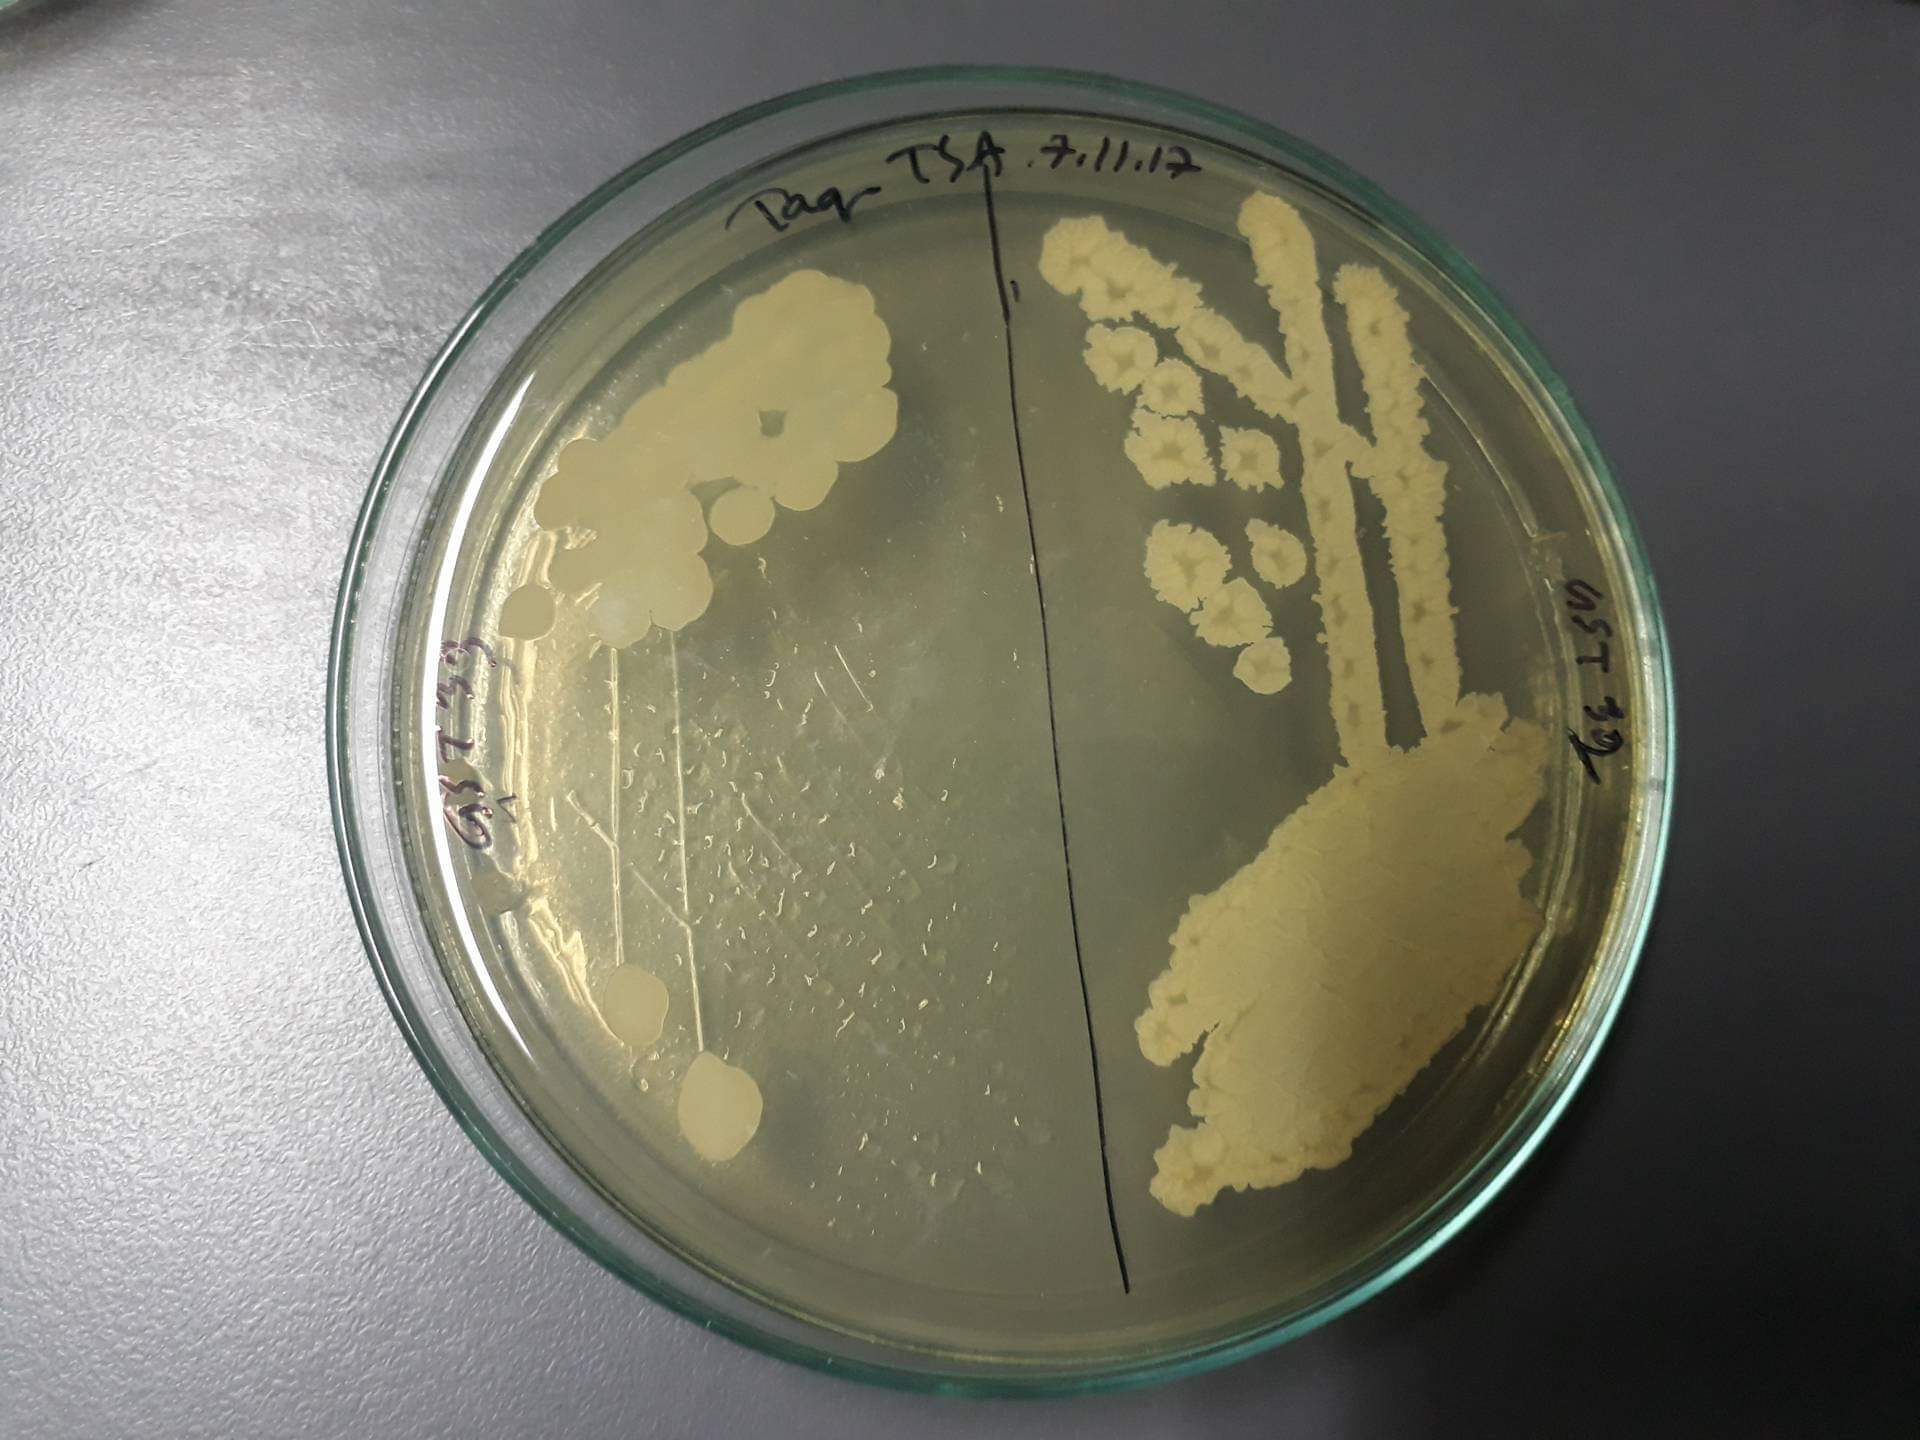
Clindamycin hydrochloride 4822

Clindamycin hydrochloride
Tocris Bioscience | Catalog # 4822


Product Description
Clindamycin hydrochloride is a lincosamide antibiotic. Inhibits protein synthesis by binding to the 50S ribosomal subunit and preventing early peptide chain elongation in bacteria.Licensing Information
Sold for research purposes under agreement from Pfizer Inc.
Product Specifications for Clindamycin hydrochloride
Molecular Weight
Formula
Storage
Purity
Chemical Name
CAS Number
PubChem ID
InChI Key
SMILES
The technical data provided above is for guidance only. For batch specific data refer to the Certificate of Analysis.
Solubility
| Solvent | Max Conc. mg/mL | Max Conc. mM | |
|---|---|---|---|
| Solubility | |||
| DMSO | 46.14 | 100 |
Preparing Stock Solutions for Clindamycin hydrochloride
The following data is based on the product molecular weight 461.44.
Batch specific molecular weights may vary from batch to batch due to the degree of hydration, which all affect the solvent volumes required to prepare stock solutions.
| Concentration / Solvent Volume / Mass | 1 mg | 5 mg | 10 mg |
|---|---|---|---|
| 1 mM | 2.17 mL | 10.84 mL | 21.67 mL |
| 5 mM | 0.43 mL | 2.17 mL | 4.33 mL |
| 10 mM | 0.22 mL | 1.08 mL | 2.17 mL |
| 50 mM | 0.04 mL | 0.22 mL | 0.43 mL |
Calculators
Background References
References are publications that support the biological activity of the product.
- Dhawan and Thadepalli Clindamycin: a review of fifteen years of experience. Rev.Infect.Dis. 1982 PMID: 6818656
- Champney and Tober Specific inhibition of 50S ribosomal subunit formation in Staphylococcus aureus cells by 16-membered macrolide, lincosamide, and streptogramin B antibiotics. Curr.Microbiol. 2000 PMID: 10856379
Product Documents for Clindamycin hydrochloride
Certificate of Analysis
To download a Certificate of Analysis, please enter a lot or batch number in the search box below.
Product Specific Notices for Clindamycin hydrochloride
For research use only
Customer Reviews for Clindamycin hydrochloride (1)
Have you used Clindamycin hydrochloride?
Submit a review and receive an Amazon gift card!
$25/€18/£15/$25CAN/¥2500 Yen for a review with an image
$10/€7/£6/$10CAN/¥1110 Yen for a review without an image
Submit a review
Customer Images
-
Species: MRSAAssay Type: In VitroVerified Customer | Posted 11/13/2018Clindamycin and Vancomycin combination therapy was studied. Susceptibility and time kill studies were carried out on MRSA.
There are no reviews that match your criteria.